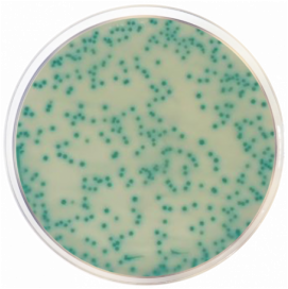
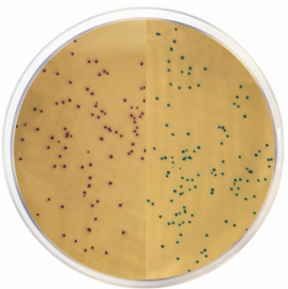

Chromogenní MRSA agar (základ)
Chromogenní, selektivní a diferenciální půda navržená pro kvalitativní přímou detekci Staphylococcus aureus rezistetních k methicilinu (MRSA) z klinických vzorků. Tento produkt je dodáván v dehydratované formě a je určen pro přípravu hotových kultivačních médií.